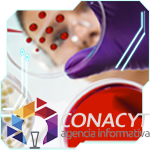

|
|
Otros boletines | Contacto |
| Comunidad CUDI |
Videoconferencia VC-CUDI
La Corporación Universitaria para el Desarrollo de Internet, A. C., pone a disposición de sus miembros, comunidades y grupos técnicos, el sistema de videoconferencia VC-CUDI, que permitirá a los usuarios utilizar modelos de comunicación y servicios de colaboración móviles y flexibles a través de Salas Virtuales en 2 modalidades:
1. Salas virtuales asignadas: sólo para asociados académicos que estén al corriente en sus cuotas; se asignará una sala virtual por institución y será su responsabilidad la administración de la misma.
2. Salas virtuales bajo demanda: para los usuarios miembros de las instituciones CUDI que estén al corriente en sus cuotas; las sesiones serán administradas por el VNOC-CUDI.
VC-CUDI
es un servicio de videoconferencia distribuida que está integrando CUDI, con el apoyo de la UNAM, la BUAP y la UDG. Se compone de 4 servidores, con capacidad de hasta 40 puertos en HD cada uno, ubicados en las instalaciones de la UNAM, BUAP y en el Data Center Cuajimalpa de KIO Networks.
Leer más |
 |
 |
Diversidad lingüística y cultural: la comunidad sorda mexicana
La comunidad de Laboratorios Compartidos presentará la primera conferencia de SEVIDA el miércoles 20 de enero a las 16:00 horas.
El objetivo de estos seminarios es el de conocer e interactuar con diferentes grupos de investigación lingüística, de profesionales de la salud y profesores líderes en el campo, promoviendo la colaboración y la docencia a través de Red Nacional de Investigación y Educación.
Para participar deberás realizar la prueba de conexión el día martes 19 de enero a las 16:00 horas.
A través de PC o MAC
1. Ingresar a: http://vc.cudi.edu.mx/
2. Se mostrará un mensaje notificando que el sitio no es seguro, debes aceptar el riesgo e ingresar.
3. Teclear el conference alias: laboratorios y su nombre, apellido e institución.
4. Dar clic en connect.
5. Compartir audio y vídeo.
Leer más |
 |
 |
Convocatoria bilateral científica y tecnológica entre México y Estados Unidos
El objetivo de esta Convocatoria es impactar en la competitividad nacional a través de apoyos que promuevan el desarrollo de un ecosistema de innovación tecnológica precompetitiva en la vinculación entre academia e industria.
El modelo operativo estará alineado y afiliado al modelo Industry/University Cooperative Research Centers (I/UCRC) de la NSF, socio estratégico en este programa.
Los interesados en participar deben pertenecer a una institución de educación superior (IES), centro de investigación (CI), instituto nacional de salud o figura académica y de investigación con programas de posgrado en el Programa Nacional de Posgrados de Calidad (PNPC) del Conacyt.
Las propuestas deben presentarse por un investigador principal con titularidad (o su equivalente) dentro de la institución proponente. Este investigador principal será inicialmente el director del consorcio en México. Un investigador principal puede participar únicamente como líder de un consorcio.
Fechas importantes:
Primer corte de recepción de propuestas: 31 de marzo de 2016
Segundo corte de recepción de propuestas: 31 de mayo de 2016
Tercer corte de recepción de propuestas: 30 de junio de 2016
Leer más .png)
|
|
 |
|
Convocatoria: Participa como conferencista en ISUM2016
La Benemérita Universidad Autónoma de Puebla (BUAP) extiende una cordial invitación a participar como conferencista en el 7º Congreso Internacional de Supercómputo en México (ISUM 2016) que se llevará a cabo en la Heroica Puebla de Zaragoza, Puebla, México, del 11 al 15 de abril de 2016.
Tienes hasta el 29 de enero para presentar ponencias y posters en idioma Inglés, de acuerdo al formato Springer LNCS:
Latex Templates: llncs2e.zip & typeinst.zip.
Word Templates: llncs_word_template.zip.
Envía el resumen de tu propuesta con un máximo de 2 cuartillas y una descripción de 50 palabras, al correo call_isum2016@redudg.udg.mx. Las presentaciones de mayor relevancia serán incluidas en las conferencias magistrales. El Comité Organizador promoverá la publicación de los mejores trabajos en una revista internacional e indexada.
El autor recibirá una notificación por correo la semana del 26 de febrero, comunicándole su aceptación.
Leer más .png)
|
 |
 |
Enseñanza de la ingeniería en sistemas preuniversitarios
La Dra. Noemí V. Mendoza Díaz, coordinadora de la comunidad de Ingeniería en CUDI, realizó un trabajo exploratorio en los Estados Unidos de América relacionado a la educación de la ingeniería en los sistemas de educación previos a la universidad, que cubren del preescolar al equivalente de preparatoria (P-12). La investigación realizada en conjunto con Mónica F. Cox, profesora asociada de la Purdue University, muestra un panorama de la enseñanza necesaria y disponible para introducir conocimientos de ingeniería a jóvenes ciudadanos y el camino que podría seguir en México, realizando las adecuaciones necesarias.
El artículo presenta un extenso resumen de la literatura acerca de la educación en ingeniería para la educación que va del preescolar al 12° grado (P-12) publicada entre 2001 y 2011.
Leer más .png)
|
 |
 |
Investigador del CIMAT realizará investigación con la
Sociedad Real de Londres
La Sociedad Real de Londres, la Academia Británica y la Academia de Ciencias Médicas dieron a conocer los ganadores de las becas de colaboración Newton para estudios avanzados que fueron aprobadas para el segundo periodo de 2015 siendo uno de los galardonados el doctor Juan Carlos Pardo Millán, investigador del área de probabilidad y estadística del Centro de Investigación en Matemáticas, A.C. (CIMAT)
Juan Carlos Pardo, quien pertenece al CIMAT desde hace más de cinco años, trabajará con el profesor Andreas Kyprianou, de la Universidad de Bath, en el tema de Procesos Estocásticos Contemporáneos con Discontinuidades de Trayectoria.
Pardo Millán obtuvo su doctorado en la Universidad de París VII en 2007.
Entre sus áreas de interés destacan los procesos de Lévy, ramificaciones continuas, autosimilares positivos y los problemas de paro óptimo, entre otros. Este año los ganadores del apoyo fueron investigadores de Brasil, China, México, Sudáfrica y Turquía. Además de Pardo Millán, otros mexicanos seleccionados fueron los doctores Guerda Massillon (UNAM), Mario Arteaga (Universidad Veracruzana) y Alejandro González Voyer (UNAM).
Leer más |
 |
 |
México, primer país en comercializar tecnología de conexión Li-Fi
La tecnología Li-Fi o Fidelidad Lumínica transmite datos de forma inalámbrica por medio de luz visible (LV) que proyectan diodos emisores de luz (LED), y logran sustituir el módem y el Wi-Fi.
México es el primer país en comercializar tecnología de conexión Li-Fi que permite la transmisión de audio, video e Internet de hasta 15 megas por segundo gracias al servicio llamado LedCom que ofrecerá la compañía Sisoft de México a partir de enero de 2016...
Leer más .png) |
 |
 |
Usuarios de Telecomunicaciones 2015 en números
El año 2015 fue de cambios importantes y notorios en las condiciones de oferta de servicios de telecomunicaciones.
La fase actual del mercado de telecomunicaciones en México se caracteriza por la intensificación de la largamente esperada competencia efectiva basada en crecientes inversiones en infraestructura, tanto en cobertura como capacidad. Sus efectos empiezan a tomar forma de mejoras en los términos de calidad, cobertura, asequibilidad y consecuente adopción de servicios.
En términos de usuarios por segmento, el de banda ancha móvil registra el mayor crecimiento anual al alcanzar un incremento de 43% en comparación con 2014 (único segmento que crecerá a doble dígito en este año), para alcanzar 32.6 millones de accesos al cierre de 2015. La dinámica de crecimiento de este servicio se sustenta en la acelerada adopción de dispositivos móviles (smartphones y tabletas), aunado al ofrecimiento de mayores capacidades de navegación a través de Internet, incluso ilimitada en el caso de aplicaciones de mensajería instantánea y redes sociales, así como al abaratamiento en su adopción...
Leer más .png) |
 |
 |
Convocatoria a participar como articulista de la Revista de Seguridad Cultura de prevención para TI en su edición número 27 de la Coordinación de Seguridad de la Información (UNAM-CERT).
La Revista Seguridad es una publicación bimestral, leída en México y Latinoamérica, que difunde investigaciones, tendencias y experiencias sobre seguridad de la información. Su objetivo es fomentar el conocimiento orientado a proteger los activos de información de las personas y las organizaciones.
El artículo puede ser reporte de casos de estudio, análisis de campo, prueba de
concepto, análisis teórico, de consejos o recomendaciones.
BASES:
1) El tema deberá estar relacionado con seguridad de la información en cualquiera de sus
alcances.
2) Enviar un resumen del artículo de no más de media cuartilla a revista@cert.unam.mx
con el asunto: “Revista .Seguridad 27 Colaboración”.
3) Adjuntar un breve resumen biográfico de no más de 8 líneas.
Vigencia: viernes 25 de enero de 2016
Leer más .png) |
 |
| |
| Las RNIEs en el mundo |
| |
La Red Nacional de Investigación y Educación de Etiopía se integra al proyecto MAGIC
Kaba Urgessa Dinassa, Ministro del Ministerio de Educación en Etiopía, y Florencio Utreras Director de MAGIC, firmaron el documento en donde se compromete la RNIE de Etiopía y MAGIC a trabajar en colaboración para cumplir con los objetivos del proyecto y de manera coordinada desarrollar las actividades en beneficio mutuo.
Leer más .png) |
 |
 |
MAGIC participó en e-AGE2015
Celebrada el 7 y 8 de diciembre de 2015 en el Hotel Sheraton Casablanca (Marruecos), y organizada por ASREN (la Red de Investigación y Educación de los Estados Árabes), la Conferencia de e -AGE (Integración de la e- infraestructura de los Estados Árabes en un Medio Ambiente Mundial) fue un excelente escenario para entender los retos que la RNIE y los investigadores árabes enfrentan con el fin de propiciar el desarrollo regional.
Leer más .png) |
 |
 |
MAS lanza libro interactivo online para acercar la astronomía a la comunidad
(REUNA)
El nuevo producto de divulgación del Instituto Milenio de Astrofísica (MAS), tiene como objetivo acercar a todo público al fascinante mundo de la astronomía, abordando de manera lúdica y sencilla conceptos básicos de esta ciencia.
Leer más .png) |
 |
 |
Una más y ya son 4 las RNIEs de América Latina que se integran a NRENum.net (RAU)
NRENum.net da la bienvenida a la Red Nacional de Investigación y Educación de Uruguay (RAU)
El 27 de noviembre del 2015, se publicó en el sitio oficial del ENUM Service for Academia, el código +598 asignado a RAU.
Leer más .png) |
 |
 |
|
|